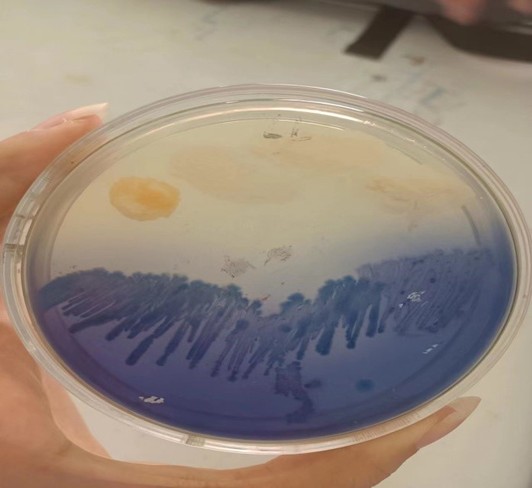
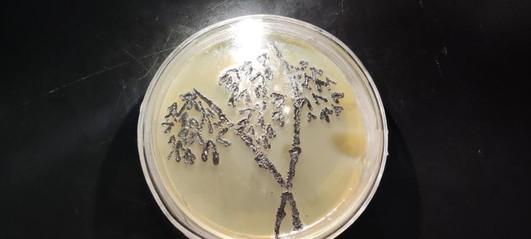
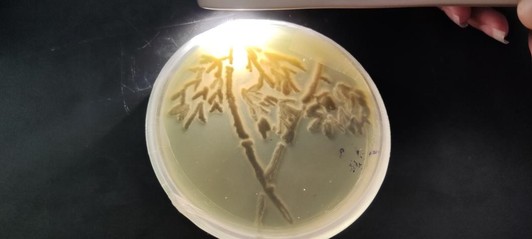
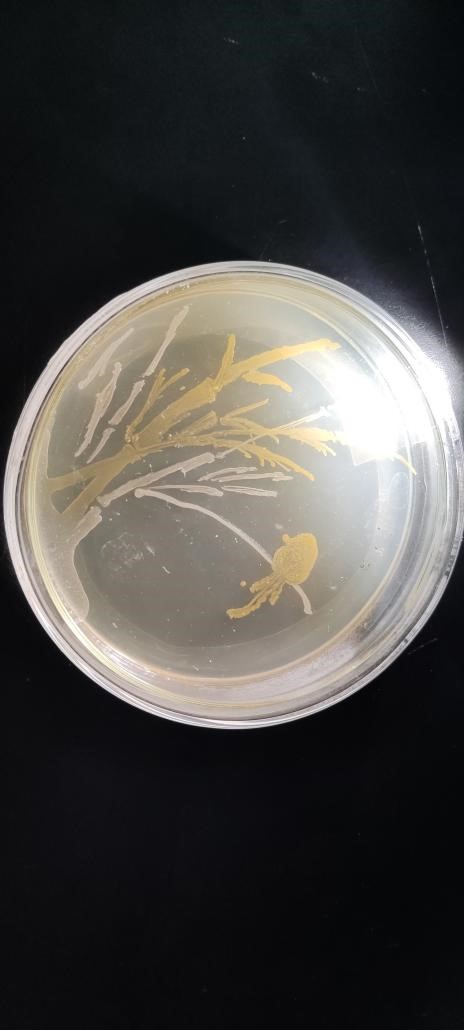
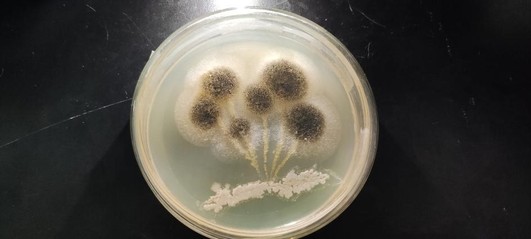
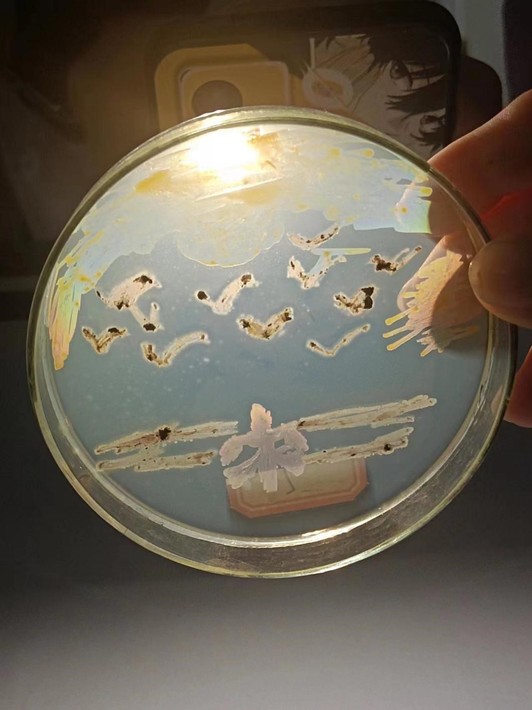
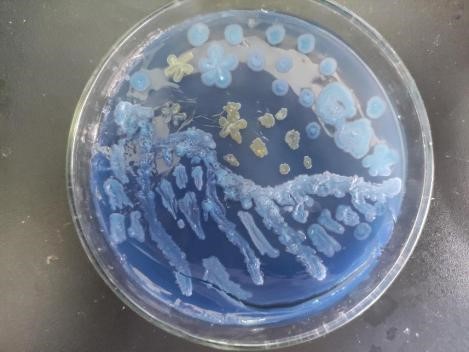

(学生通讯员 徐海锦 李敏 易思敏 陈小雪)为激发同学们对于微生物的热爱,调动大家的创新积极性,同时培养团队协作能力,4月17日至28日期间,我院在理工楼微生物与免疫实验室举办第一届微生物艺术大赛。本次大赛由我院生物教研室王瑞君、吕美云和刘紫英三位老师担任指导评审老师,21级生物工程班级全体学生参加比赛。

王瑞君老师为参赛学生授课
大赛伊始,王瑞君老师就微生物艺术创作原理为参赛同学进行授课,讲课中强调微生物培养基制作及细菌、真菌、放线菌培养过程中的注意事项,不同菌种在不同培养基上长出的颜色及形态。随后,同学们开始欣赏国内历届大赛的优秀作品并从中获取灵感,理清创作思路。接着,根据参赛同学自由组合班级随机分成了九组,在明确分组创作任务后,各组队员们积极参与,有序地进行固、液培养基的制作,对目的菌株进行扩大培养,在培养皿中绘制出精美细菌的图案。制作过程中,王瑞君耐心地为同学们解疑答惑,并给予正确的指导,还鼓励同学们拓宽创新思路、专注创作。

参赛学生开始制作培养基
作品主题:旭日东升,海面汹涌,乘风破浪!

作品主题:梅兰竹菊——无梅花,无霉运。

作品主题:惬意的田园世界
作品主题:滕王阁序中落霞与孤鹜齐飞秋水共长天一色

作品主题:美丽的海洋世界
参赛学生的部分作品
经过10天的耐心培养和细心呵护,同学们将所准备好的微生物培养皿交于指导老师进行评审,老师们通过培养皿中的绘图以及同学们对作品的讲解介绍进行评判,最终评选出一等奖1项、二等奖2项、三等奖4项,个人最佳创意奖5项。由谢冰幸,李星辰,汪洁组成的小组获得一等奖,谢冰幸、罗坤、李星辰、杨采璐、任昕获得个人最佳创意奖。之后,老师们为获奖同学颁发了奖状并合影留念。至此,大赛圆满落下帷幕。

一等奖获得者合影

个人最佳创意奖获得者合影

获奖同学合影
此次大赛的开展,一方面加强了学生们的创新思维和实践动手能力,另一方面也提升了大家对专业知识的深刻理解,为实践创新打下了坚实的基础,也展现出我院学子们团结协作、标新立异的良好学习氛围。
责编:龚文磊
审核:陶华蕾